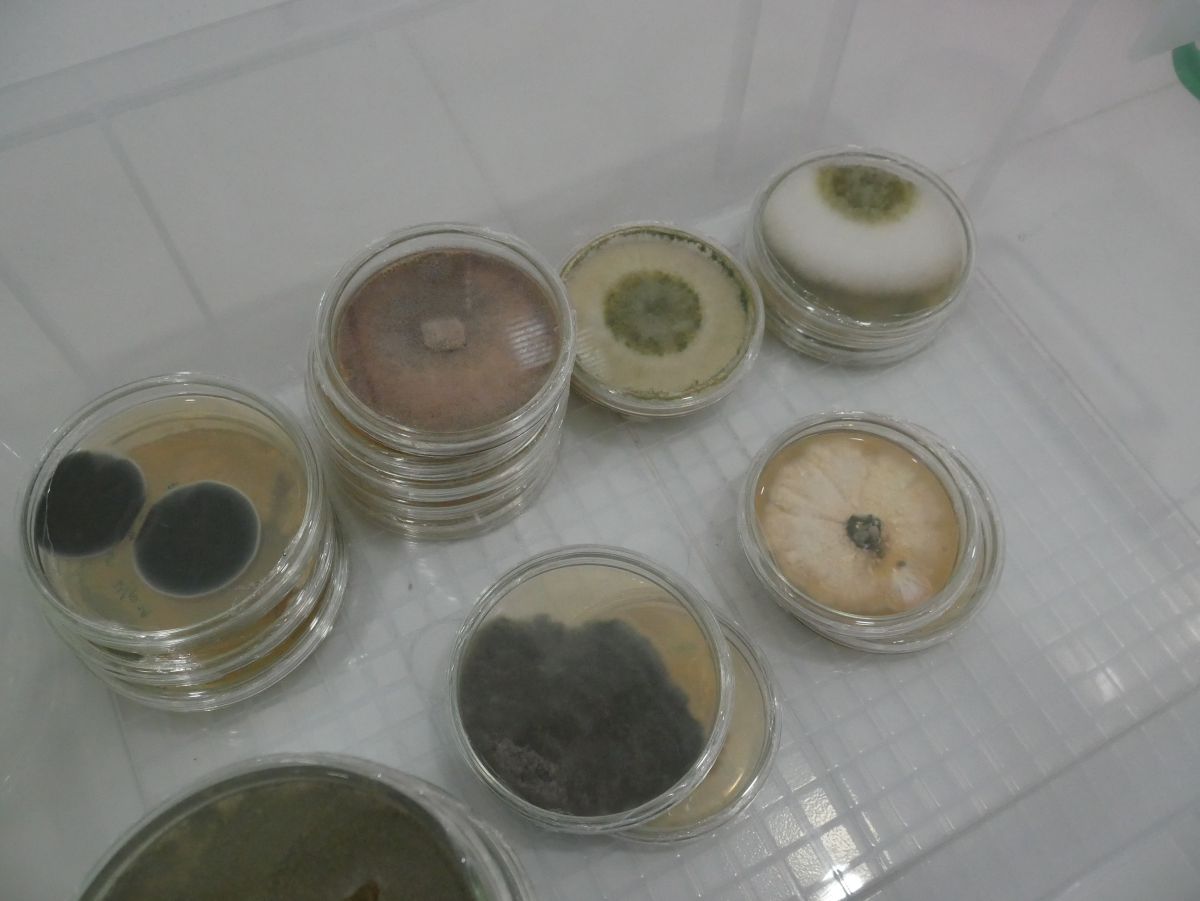
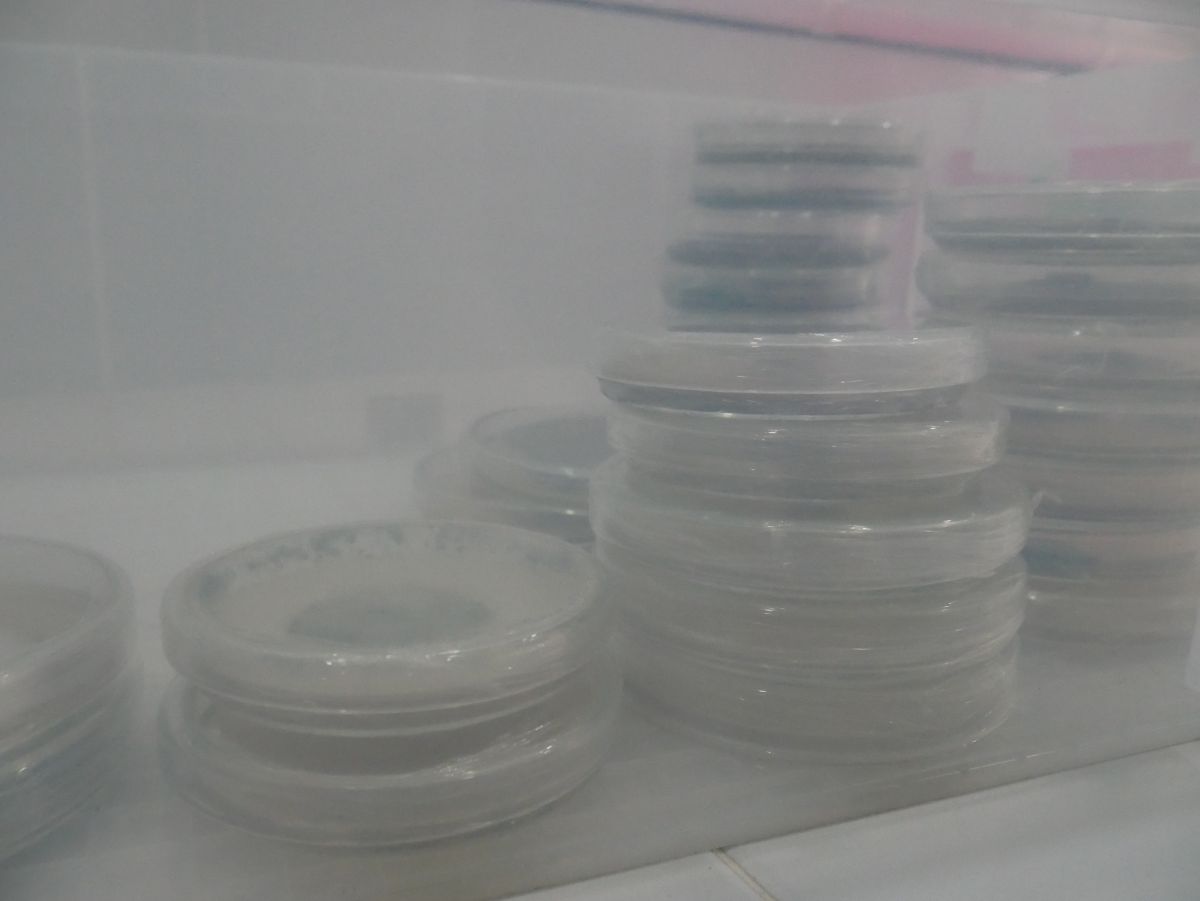

Isolasi Jamur Laut - Laboratorium Mikrobiologi
- 0 /5.0 Ulasan pengguna
- 0 Penjualan
- 1 Tampilan
- Save
Deskripsi Layanan
Layanan Isolasi Jamur Laut
Layanan isolasi jamur laut merupakan jasa layanan untuk memperoleh isolat jamur murni yang berasal dari sampel lingkungan laut maupun organisme laut, dan pesisir. Proses isolasi dilakukan menggunakan teknik mikrobiologi standar meliputi homogenisasi sampel, dilusi/pengenceran bertingkat, dan penanaman dengan metode spread plate/cawan sebar pada media yang disesuaikan dengan karakteristik jamur laut.
Data Output
Output jasa layanan berupa isolat murni/koloni tunggal yang disimpan di dalam tabung kaca miring, dokumentasi foto koloni mikroba, dan data karakteristik makroskopik mikroba.
Jenis Sampel yang Dapat Diproses
- Sampel lingkungan: Air laut dan sedimen laut
- Sampel biologis laut dan pesisir
Cakupan Layanan
- Penyediaan media kultur untuk proses isolasi menggunakan Malt Extract Agar (MEA) dan Potato Dextrose Agar (PDA).
- Layanan isolasi tersedia untuk berbagai jumlah target mikroba, yaitu 5–10 isolat jamur, 11–20 isolat jamur, dan 21–30 isolat jamur.
Persyaratan Sampel
- Pengiriman sampel wajib dikonfirmasikan terlebih dahulu kepada laboran sebelum dilakukan pengiriman.
- Waktu transportasi sampel tidak melebihi 48 jam sejak pengiriman.
- Sampel harus dikemas menggunakan cool box atau kotak styrofoam yang dilengkapi ice pack untuk menjaga kestabilan suhu selama proses transportasi.
- Setiap sampel wajib dilengkapi identitas yang jelas, meliputi label atau kode sampel, jenis sampel, serta berat atau ukuran sampel.
Pertanyaan yang sering diajukan
-
Bagaimana cara menggunakan layanan laboratorium di MERO Foundation?
Untuk menggunakan layanan laboratorium kami, ikuti langkah berikut:- Pastikan Anda sudah registrasi menggunakan akun Gmail Anda
- Pilih layanan laboratorium yang sesuai dengan kebutuhan penelitian Anda
- Lakukan pembayaran sesuai metode yang tersedia
- Isi dokumen informasi sampel dan kebutuhan analisis
- Kirim sampel Anda ke alamat laboratorium kami
- Gunakan fitur chat untuk mengetahui progress pengerjaan layanan Anda
-
Bagaimana cara melakukan pembayaran layanan?
Pembayaran layanan dilakukan secara manual dengan mengupload bukti pembayaran ke sistem. Kami menyediakan 2 metode pembayaran:- Pembayaran FULL - bayar total harga layanan sekaligus
- Pembayaran UANG MUKA (Down Payment) - bayar 60% di awal, sisanya 40% setelah pekerjaan selesai
Setelah melakukan transfer, silakan upload bukti pembayaran di halaman order Anda. -
Apa yang harus dilakukan setelah melakukan pembayaran?
Setelah melakukan pembayaran dan mengupload bukti transfer, Anda dapat melakukan konfirmasi pembayaran melalui 2 cara:- Hubungi kontak resmi MERO Foundation yang tertera di website
- Gunakan fitur chat di dalam aplikasi
Pastikan Anda login dengan akun yang sama saat melakukan order agar kami dapat memverifikasi pembayaran Anda dengan cepat dan memulai proses pengerjaan. -
Apa saja hasil yang akan saya terima dari layanan laboratorium?
Setiap layanan memberikan hasil lengkap dan siap publikasi:- Uji Mikrobiologi: Laporan zona hambat, foto dokumentasi, dan interpretasi hasil
- Layanan Molekuler: File sekuens DNA (FASTA), kromatogram, hasil BLAST, dan identifikasi spesies
- Layanan Kimia: Foto TLC dengan nilai Rf dan analisis senyawa
- SEM: Foto high-resolution dengan scale bar
Semua hasil dikirim dalam format digital (PDF dan raw data) melalui email atau dashboard Anda, lengkap dengan sertifikat analisis. -
Bagaimana persyaratan dan cara pengiriman sampel ke laboratorium?
Persyaratan sampel berbeda untuk setiap layanan:- Uji Antibakteri: Minimal 2ml ekstrak cair atau 30mg padat
- DNA Ekstraksi: Minimal 10ml sampel
- Identifikasi Plankton: Minimal 50ml sampel terkonsentrasi dengan preservasi Lugol atau formalin 4%
- Sampel Biologis: Diawetkan dalam etanol 70-96% atau formalin 10%
- DNA: Dikirim dalam kondisi dingin atau beku
Alamat Pengiriman:
MERO Foundation Laboratory
Banjar Dinas Muntig, Tulamben, Kubu
Karangasem, Bali 80853
Hubungi kami via chat aplikasi atau kontak tertera untuk panduan packaging detail sebelum mengirim sampel Anda. -
Bagaimana cara berkomunikasi dengan tim laboratorium untuk konsultasi dan update progress?
Anda dapat berkomunikasi dengan tim laboratorium melalui beberapa cara:- Fitur CHAT di dalam aplikasi setelah login - cara tercepat untuk real-time communication
- Dashboard akun Anda untuk cek status progress pengerjaan
- Kontak resmi yang tertera di halaman layanan untuk konsultasi teknis
- Email untuk pertanyaan detail metodologi atau hasil analisis
Tim kami responsif dan siap membantu dari persiapan sampel, konfirmasi penerimaan, hingga interpretasi hasil.
Untuk layanan sequencing DNA, kami bekerja sama dengan PT. Genetika Sains Indonesia untuk menjamin kualitas hasil terbaik.
 (1).png)